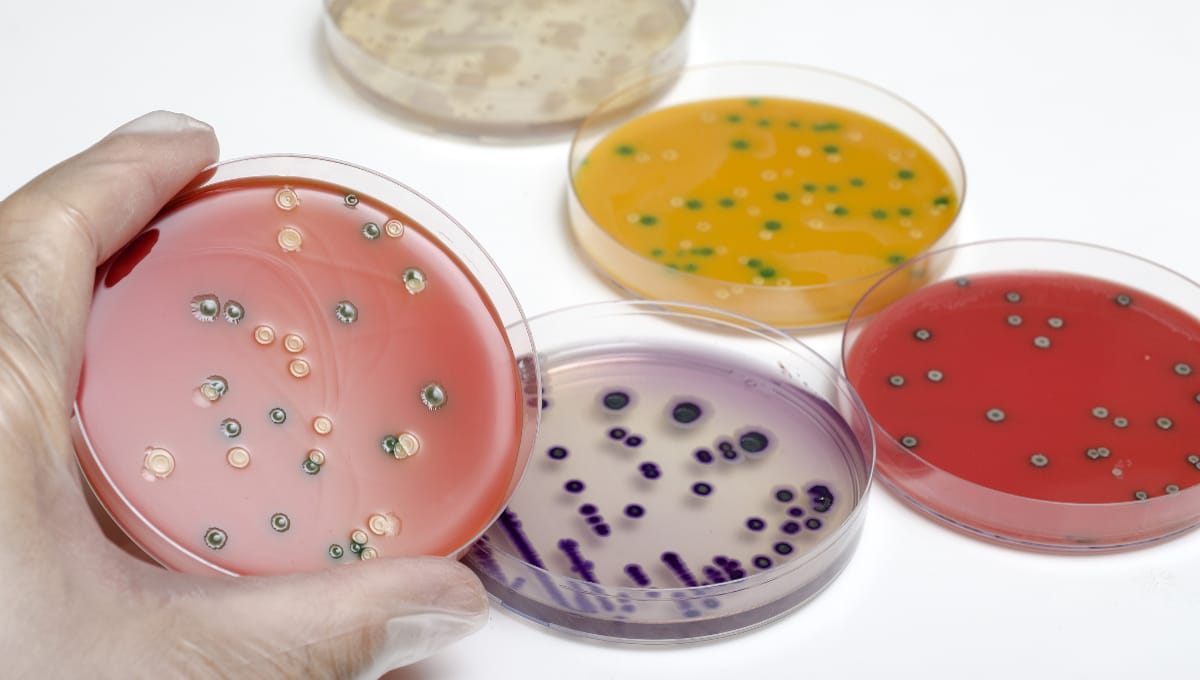

Salmonella caused almost a quarter of foodborne outbreaks in Europe in 2020, according to a report.
The main sources of salmonellosis outbreaks were eggs, egg products and pig meat. Norovirus in crustaceans, shellfish, mollusks and products containing them and Listeria monocytogenes in fish and fish products were other agents and food pairs of concern.
A total of 3,086 foodborne outbreaks were reported in 2020 – a 47 percent decrease from 2019 – and 20,017 cases – a 61.3 percent decrease. There were also 1,675 hospitalizations and 34 deaths this past year compared to 4,298 and 60 in 2019. The agent was unknown for more than 1,200 outbreaks that affected 6,139 people. These were primarily notified by Belgium and Netherlands.
The number of outbreaks in Belgium, France, Germany, the Netherlands and Slovakia made up more than three-quarters of the total. France had more than 1,000, Netherlands had 559 and Belgium 331.
Differing COVID-19 impact
Lower figures are mainly due to the COVID-19 pandemic leading to reduced exposure of people to contaminated food and a higher under-reporting of outbreaks. Withdrawal of the United Kingdom from the EU contributed only marginally to the decrease, found the European Food Safety Authority (EFSA) and European Centre for Disease Prevention and Control (ECDC) report.

The fall did not affect all pathogens equally. Outbreaks caused by agents associated with severe clinical conditions such as botulism, listeriosis, trichinellosis and E. coli declined less than those from other agents or not at all. Outbreaks due to norovirus and Hepatitis A dropped sharply in 2020 to 130 and seven, respectively, from 458 and 20 in 2019.
General outbreaks were more frequent than household outbreaks. However, compared with 2019, general outbreaks decreased to a greater extent than household ones.
Another 57 outbreaks, 1,496 illnesses, 155 hospitalizations and 14 deaths were reported by seven non-member states in 2020. The UK had 30 outbreaks affecting 1,148 people with four deaths.
One outbreak caused by table eggs contaminated with Salmonella Enteritidis was reported in the UK as a continuation from the previous year involving 59 cases. Two deaths were recorded in an incident linked to smoked salmon caused by Listeria monocytogenes. Two milk-borne outbreaks caused by Campylobacter and one by STEC O157 were reported as well as an outbreak of Clostridium perfringens linked to spreadable cheese.
Campylobacter and Salmonella outbreaks
Campylobacter outbreaks were reported by 17 member states. In total, 317 outbreaks included 1,319 illnesses, 112 hospitalizations and no deaths. Eleven had strong evidence and 306 had weak evidence. The most common food vehicles for the strong-evidence outbreaks were broiler meat and raw milk, as in previous years. In 2019, 319 outbreaks were recorded with 1,254 cases.
Two large outbreaks caused by Campylobacter jejuni were reported by Denmark and Sweden involving 161 cases with 33 hospitalizations and 150 cases, respectively. Contamination of milk at a processing plant was implicated in the first event, while the other was caused by chicken meat.
In total, 694 foodborne outbreaks of Salmonella were reported by 22 nations, causing 3,686 illnesses, 812 hospitalizations and seven deaths. More than half of them were caused by Salmonella Enteritidis. The three food vehicles mainly involved in strong-evidence outbreaks were eggs and egg products, pig meat and products and bakery products. In 2019, 1,284 outbreaks caused 10,240 illnesses.
Salmonella Muenchen was responsible for an outbreak in Germany with 161 cases due to contamination of coconut pieces or flakes. In Italy, Salmonella Enteritidis was behind an outbreak linked to cheese that caused 86 cases, eight hospitalizations and one death. An outbreak in Hungary linked to sweets and chocolate involved 78 cases and seven hospitalizations.
The role of poultry products as a risk for Salmonella infections was confirmed by a multi-country outbreak due to Salmonella Enteritidis affecting 193 people in eight EU countries and the United Kingdom from 2018 to 2020.
Listeria behind half of deaths in outbreaks
Listeria monocytogenes caused 16 foodborne outbreaks involving seven countries and 120 cases, 83 hospitalizations and 17 deaths. Overall, 34 people were hospitalized in Germany; 24 in the Netherlands; 14 in Finland; seven in Italy; and two in both France and Austria. In 2019, 21 outbreaks led to 349 illnesses.
Nine outbreaks were reported with strong evidence and eight with weak evidence. Six strong-evidence outbreaks were caused by fish and fishery products with two each in Netherlands and Denmark and one each in Austria and Germany; two were caused by meat and meat products in Finland; and one by cheese in the Netherlands. An outbreak in Switzerland caused the most deaths ever detected in a single event in Europe with 10 and was traced to cheese.
Nine countries reported 34 STEC outbreaks, 208 cases, 30 hospitalizations and one death in 2020. In 2019, 42 outbreaks affected 273 people.
STEC O157, O145 and O26 were identified in three, two and one outbreak, respectively. Almost half of them were recorded in Ireland. Six O157 and one O145 outbreak were reported by the UK.
Sources in the five strong-evidence outbreaks were water twice, and meat and meat products, dairy products other than cheese and cheeses made from cows’ milk all once.
Toxins, viruses and parasites
One brucellosis outbreak was reported by Austria because of Brucella melitensis in sheep meat products, affecting two people from the same household, who contracted the infection abroad. Both were hospitalized.
There were five strong-evidence Trichinella outbreaks and one with weak-evidence leading to 119 illnesses, 13 people hospitalized and no deaths. The biggest was in Italy with 79 cases. In 2019, five outbreaks sickened 44 people.
In the strong-evidence outbreaks, the food vehicles were fresh raw sausages from wild boar meat, pig meat and products thereof, other or mixed red meat products, meat and meat products, and fresh pig meat. Two strong-evidence outbreaks were reported by Serbia with eight confirmed cases, seven hospitalizations and no deaths.
In Czech Republic, one outbreak caused 131 cases of Hepatitis A with 91 needing hospitalization. Another large outbreak in Germany involved 41 cases with nine hospitalizations. No information on the implicated vehicle was available for either event. There were five outbreaks of tick-borne encephalitis involving 12 patients, all requiring hospitalization. Raw sheep’s milk and/or raw goat’s milk was the vehicle in all of them.
Two outbreaks of Anisakis affected six people, three of Cryptosporidium sickened 34 and a Enterocytozoon bieneusi outbreak affected 77 in Denmark. Yersinia was behind 16 outbreaks with 236 illnesses. Shigella caused five outbreaks with 58 patients and Vibrio parahaemolyticus had four outbreaks with 56 cases.
Bacillus cereus was linked to 71 outbreaks with 835 sick, Clostridium botulism to nine incidents with 34 cases, Clostridium perfringens in 32 outbreaks with 682 illnesses, and Staphylococcus aureus in 43 outbreaks with 402 patients.
A total of 43 histamine and Scombrotoxin outbreaks affected 183 people and 23 marine biotoxin incidents sickened 120. In nine outbreaks, food poisoning was caused by ciguatoxin, the causative agent of Ciguatera fish poisoning. Three outbreaks of lectin poisoning were reported by Denmark, involving 55 people.
(To sign up for a free subscription to Food Safety News, click here)